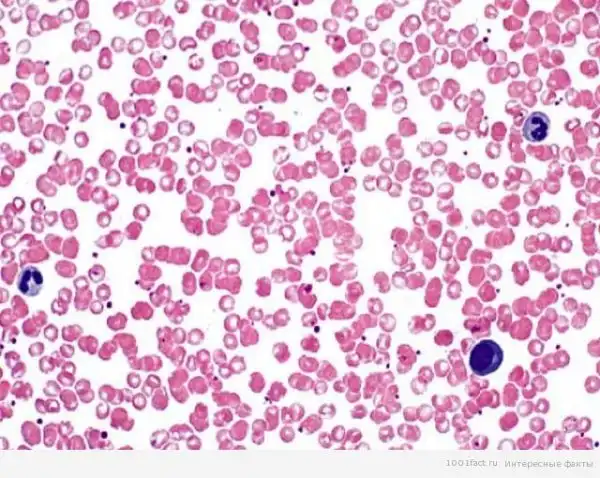

Все знают, что кровь человека красного цвета. Это связано с наличием в ней железа для транспортировки кислорода.
Клетки крови постоянно обновляются. Старые отмирают, их заменяют новые, образовавшиеся в селезенке и костном мозге. За месяц, в среднем, обновляется 1 литр крови. А гной, который образовывается в травмированном месте – это лейкоциты, которые не справились с инфекцией и погибли.
Клетки крови постоянно обновляются. Старые отмирают, их заменяют новые, образовавшиеся в селезенке и костном мозге. За месяц, в среднем, обновляется 1 литр крови. А гной, который образовывается в травмированном месте – это лейкоциты, которые не справились с инфекцией и погибли.
Группа крови не меняется, но количество кровяных клеток изменяется в зависимости от состояния организма и возраста.
У женщин на первых неделях беременности повышается количество лейкоцитов, а у новорожденных малышей в литре крови на 1-2 млн. эритроцитов больше, чем в литре крови любого взрослого человека.
Пациэнтам с IV группой крови для переливания может подойти любая группа. А люди, у которых I группа крови, могут быть донорами на всех остальных групп.
Скорость течения крови по сосудам – примерно 2 км/час, а за сутки сквозь сердце проходит около 10 тысяч литров «жидкости жизни». При этом у женщин эта цифра больше, т.к. их сердце в минуту делает на 7-8 ударов больше.
А в Японии считается, что темперамент и характер человека зависит от группы крови больше, чем от даты рождения. Поэтому многие больше доверяют характеристике группы крови, чем гороскопам по знаку зодиака.